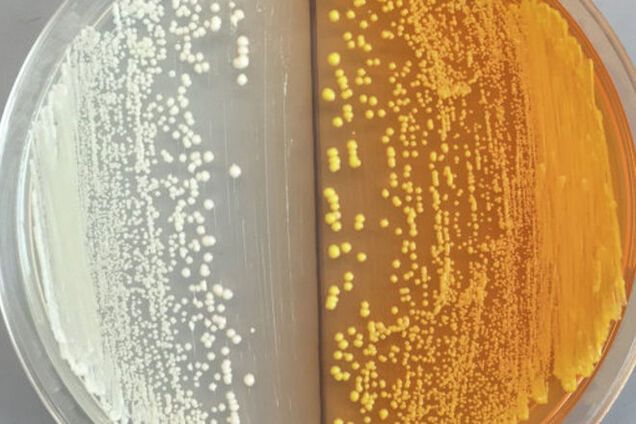
Ученые научились превращать дрожжи в наркотики

Ученые научились превращать дрожжи в наркотики
Генетики вывели новый сорт генно-модифицированных дрожжей, которые превращают сахар в сырье для изготовления опиатов и ряда лекарственных препаратов.
"Что нам реально хочется сделать – скармливать дрожжам глюкозу и научить ее исполнять все химические шаги, необходимые для производства молекул того лекарства, которое вам нужно. В нашем исследовании мы описали каждую из этих ступеней, и теперь их осталось лишь связать между собой и довести их до промышленного уровня. Это сложно, но осуществимо", — рассказал Джон Дюбер из университета Конкордии в Квебеке (Канада), передает РИА Новости.
Дюбер и несколько других биоинженеров сделали потенциально опасный шаг в сторону синтетических опиатов, пытаясь воспроизвести внутри дрожжей работу наиболее сложной части той цепочки ферментов, которая отвечает за производство морфина и прочих опиатов в клетках мака.
Читайте: Ученые нашли в космосе гигантские спирали, которые объяснят суть Вселенной
Эта часть "конвейера" отвечает за сборку молекул так называемых бензил-изо-хинолинов (БИХ) – сложных органических молекул из трех углеводородных колец, составляющих основу морфина, кодеина, ряда других опиатов, а также несколько десятков антираковых и антиконвульсивных лекарств, которые можно найти внутри маковых кубышек.
Подобные молекулы склеиваются в клетках мака из двух молекул аминокислоты тирозина, которые особым образом окисляются и меняются перед соединением. Воспроизведение этой фазы вызывало большие трудности у биохимиков, так как в клетках дрожжей отсутствуют нужные детали этого "конвейера".
Читайте: Все дело в руках: ученые обвинили Венеру Милосскую в проституции
Группа Дюбера решила эту проблему, вставив в геном дрожжей ген другого растения – обычной свеклы, который позволил дрожжам превращать тирозин в дофамин, гормон удовольствия и одну из "половинок" молекул БИХ.
Подобный прием позволил ученым воспроизвести примерно половину звеньев цепочки, отвечающей за производство морфина и прочих опиатов. Учитывая то, что другие части этого конвейера были воспроизведены еще в 2008 и в 2011 году, теперь у биотехнологов есть возможность вырастить полноценные опийные дрожжи, объединив эти наработки.
"В принципе, любой человек, обладающий доступом к такому сорту дрожжей и обладающий базовыми навыками по их ферментации, сможет вырастить грибок, производящий морфин, используя обычный набор для домашнего пивоварения", - отметила Таня Бубела из университета провинции Альберта в Эдмонтоне (Канада), эксперт-биотехнолог, не связанный с авторами научного исследования.
Читайте: Пища богов: ученые определили самую аппетитную еду
По ее словам, по этой причине все подобные исследования должны проводиться под контролем со стороны наркологических служб, и доступ к их выводам, а также к самим образцам дрожжей, должен быть строго ограничен. Как отмечает эксперт, если такие дрожжи попадут в руки наркокартелей в Мексике или в других неблагополучных странах, то подавить производство таких опиатов будет практически невозможно.









